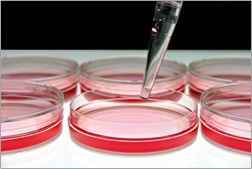

サロンを始めて7年目頃、お客様のお肌に触れてきて一つの疑問を感じるようになりました。
それは、同じ施術を提供しても、結果・効果の出る人出づらい人がいるということ。
喜びのメッセージや感謝されるとやはり存在価値を感じて「やってて良かった。。。」とつくづくうれしい気持ちになるのですが、
「あと何回通えば効果でますか??」と、あまり実感してもらえずにお帰りになるお客様もいらっしゃると、本当に「同じ施術をしているのになぜ??」と悲しい気持ちが膨らみ、その理由もわからず考え込む日々が続きました。
そんな気持ちが続いたある時
「私が今迄提供してきたことは、ハンドや、エステ機器などを使った外から何かを補う技術を提供することでした。
そうではなくお客様自身の中へ直接働きかけること=細胞レベルのもの→お肌の土台をつくる細胞そのものを元気にする、内側からの何かが必要なのではないか!?」
という考えにたどり着きました。
そして、いつの日かそのような化粧品が作れないか?と思うようになりました。
といってもきゅうりやヘチマパックというわけにはいきません。。。
答えは見つからず数年たったある日、知人の紹介でマリーブ化粧品の小林社長とお話をする機会がありました。
私は長年の疑問を社長にぶつけました。


後日、小林社長から電話がありました。
「余計な成分は全て排除した、細胞に働きかける成分だけの美容液が完成した」とのことでした。
細胞に働きかける成分とは、一般にサイトカインと呼ばれるぺプチドと言うアミノ酸が特有の結合をした物質の一種でした。
それから、私は化粧品に使用できる肌細胞に良いサイトカインを細かく調べるようになりました。

皆さんご存知のヒアルロン酸、アルブチン、コラーゲン、プラセンタ…様々な有名な成分がたくさん入っていればいるほど相乗効果が高まると思っていましたが、実はそうではないことを知ったのです。
「肌の土台を作る」ために有効な成分だけをシンプルに突き詰めるとサイトカインという成分に行き着いたのです。
更に様々な文献を読み調べ始め、肌細胞に働きかけるサイトカインEGF、FGF、TRX、IGF、TGFの5種を配合することができないものかと、小林社長のもとを訪ねました。
話を切り出すなり「そんな高価なもの、出来るわけないじゃないか!」と一言で話が終わってしまい、
その日は泣く泣く一人新幹線で帰る事になってしまいました。
諦めきれず何度となくお願いをした結果、ある日社長から「ちょっと見せたいものがある」と電話がありました。
成長因子による細胞変化をデータにした難しい表と写真の数々でした。
それから半年、何とか原材料の調達に成功し
ようやく私の追い求めていた“モノ”
“GF5バージンホワイトエッセンス”が完成しました。

より細胞に働きかけるよう、成分をナノカプセルに閉じ込める最先端の技術も取り入れました。
自ら潤いを作り出す能力を高めてくれる、まさに『肌の土台作り液』。

サロンのお客様から口コミで広まり、たいそうな広告や宣伝もせずに2年間で約20,000本も売れる商品となりました。
お客様から「もう、手放せない!」とか「GF5のおかげで若返ったみたい」といったお言葉を頂き、何年も悩んで疑問を追及した甲斐があったと感じています。


そして今回、小林社長にまたさらにシミ対策に効果のあるものを・・・と、無理をお願いして、女性の敵‘メラニン’の生成をブロックし、サイトカインの働きを助けてくれるASP(ペンタペプチド-13)を新配合したモノに“GF5バージンホワイトエッセンス”は進化致しました。
しかも成分濃度を1PPMから84.16PPMへと大幅にアップさせています。
お客様の何気ない質問から始まり苦悩と模索の長い月日から抜け出し、ようやく完成したひとつの夢の形“肌の土台作り液”を、一人でも多くの皆様にお使い頂き、私と共にエイジレスを目指していって欲しいと願っております。
皆様の肌細胞同様“GF5”もずっと、生まれ変わっていきます・・・。

